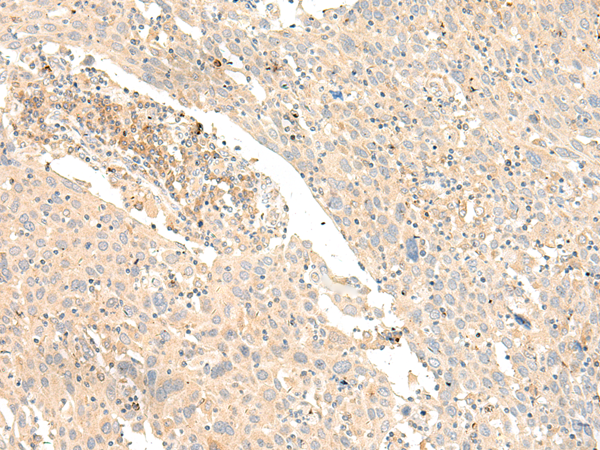
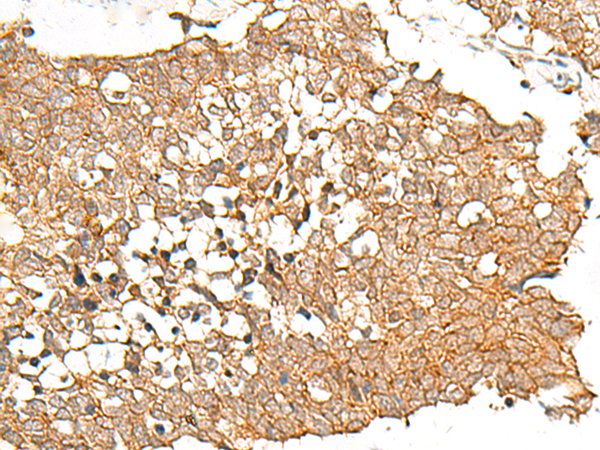

-
分类: 科研抗体货号: P13464别名:应用: IHC反应种属: Human
-
分类: 科研抗体货号: P13495别名: RP78; SA-RhoGEF; p114RhoGEF; P114-RhoGEF应用: WB反应种属: Human
-
分类: 科研抗体货号: P13484别名: GPR116; KPG_001应用: WB,IHC反应种属: Human
-
分类: 科研抗体货号: P13494别名: ATP5I; ATP5K应用: WB,IHC反应种属: Human, Mouse, Rat
-
分类: 科研抗体货号: P13499别名: LDHM; GSD11; PIG19; HEL-S-133P应用: WB,IHC反应种属: Human, Mouse, Rat
-
分类: 科研抗体货号: P13482别名: GR3; GPR10; PrRPR应用: IHC反应种属: Human
-
分类: 科研抗体货号: P13492别名: SNAP19应用: IHC反应种属: Human, Mouse
-
分类: 科研抗体货号: P13498别名: CD113t-C; beta-globin应用: WB,IHC反应种属: Human, Mouse, Rat
-
分类: 科研抗体货号: P13508别名: GPCR8; KPG_005应用: WB,IHC反应种属: Human
-
分类: 科研抗体货号: P13491别名: RBP10; RPB10; RPABC5; RPB7.6; hRPB7.6; RPB10beta应用: IHC反应种属: Human, Mouse

鄂公网安备42018502007531号
鄂公网安备42018502007531号

